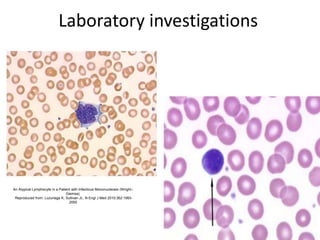
Laboratory investigations
An Atypical Lymphocyte in a Patient with Infectious Mononucleosis (Wright–
Giemsa).
Reproduced from: Luzuriaga K, Sullivan JL. N Engl J Med 2010;362:1993-
2000

This document discusses Epstein-Barr virus (EBV) infectious mononucleosis. It defines EBV and describes the typical clinical presentation of fever, pharyngitis, lymphadenopathy, and fatigue. Complications are outlined as neurological, hematological, splenic rupture, respiratory, or hepatic issues. Risk factors include people ages 15-30 and those with frequent social contact. Diagnosis involves history, exam findings, and lab tests like mono spot testing and antibody levels. Treatment is generally supportive with rest, hydration, and pain medications while monitoring for complications.